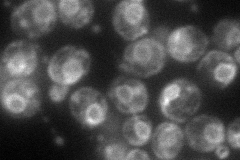
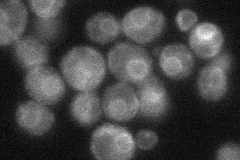
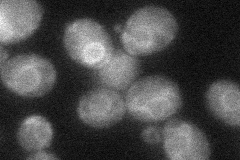

View description
Mannosyltransferase that catalyzes two consecutive steps in the N-linked glycosylation pathway; alg2 mutants exhibit temperature-sensitive growth and abnormal accumulation of the lipid-linked oligosaccharide Man2GlcNAc2-PP-Dol
Localization:
Intensity:
Fold change:
Significance:
-
C’ GFP library in SD

below threshold16.08 -
N' NOP1pr-GFP in SD
ER83.7657 -
N' TEF2pr-mCherry in SD

ER136.929 -
N' NATIVEpr-GFP in SD
ER34.5521 -
N' TEF2pr-VC and Cyto-VN in SD
ER38.7118 -
C’ GFP library in SD+DTT

cytosol17.511.08No -
C’ GFP library in SD+H2O2

cytosol17.221.07No -
C’ GFP library in Starvation Media

cytosol16.161No -
C’ GFP library on the background of Pup2-DaMP

below threshold -
C’ GFP library on the background of CCT mutant

below threshold19.6161.21929No
